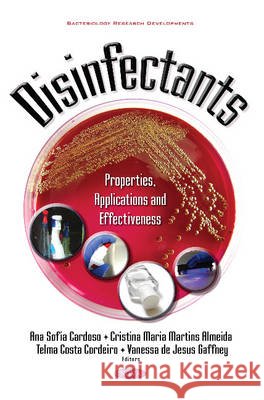
Disinfectants: Properties, Applications & Effectiveness Ana Sofia Cardoso, Cristina Maria Martins Almeida, Telma Costa Cordeiro, Vanessa de Jesus Gaffney 9781634859585 Nova Science Publishers Inc - książka

Disinfectants: Properties, Applications & Effectiveness » książka
topmenu
Disinfectants: Properties, Applications & Effectiveness
ISBN-13: 9781634859585 / Angielski / Twarda / 2016 / 340 str.
Kategorie:
Kategorie BISAC:
Wydawca:
Nova Science Publishers Inc
Język:
Angielski
ISBN-13:
9781634859585
Rok wydania:
2016
Dostępne języki:
Angielski
Wydanie:
UK
Ilość stron:
340
Waga:
0.75 kg
Wymiary:
26.026.0 x 18.0
Oprawa:
Twarda
Wolumenów:
01